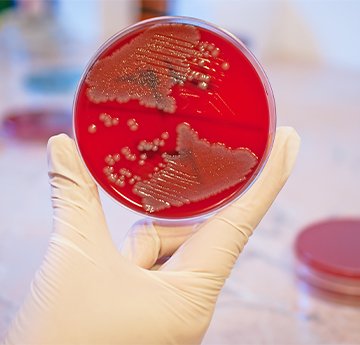

2020
Ortiz-Monslave S, Gutterres M, Valente P, Plácido J, Bustamante-López S, Kelly D, Kelly SL. Degradation of a leather-dye by the combination of depolymerised wood-chip biochar adsorption and solid-state fermentation with Trametes villosa SCS-10. Bioresources and Bioprocessing. 2020, https://bioresourcesbioprocessing.springeropen.com/articles/10.1186/s40643-020-00349-z.
Lamb DC, Hargrove TY, Zhao B, Wawrzak Z, Goldstone JV, Nes WD, Kelly SL, Waterman MR, Stegeman JJ, Lepesheva GI. Concerning P450 evolution: structural analyses support bacterial origin of sterol 14α-demethylases. Molecular Biology and Evolution. 2020, doi: https://doi.org/10.1093/molbev/msaa260.
Poloni NM, Carvalho G, Vicentini SNC, Dorigan AF, Maciel JLN, McDonald BA, Moreira SI, Hawkins N, Fraaije BA, Kelly DE, Kelly SL, Ceresini PC. Widespread distribution of resistance to triazole fungicides in Brazilian populations of the wheat blast pathogen. Plant Pathology. 2020, https://doi.org/10.1111/ppa.13288.
Binjubair FA, Parker JE, Warrilow AG, Puri K, Braidley PJ, Tatar E, Kelly SL, Kelly DE, Simons C. Small-Molecule Inhibitors Targeting Sterol 14α-Demethylase (CYP51): Synthesis, Molecular Modelling and Evaluation Against Candida albicans. ChemMedChem. 2020, doi: 10.1002/cmdc.202000250.
Rybak JM, Muñoz JF, Barker S, Parker JE, Esquivel BD, Berkow EL, Lockhart SR, Gade L, Palmer GE, White TC, Kelly SL, Cuomo CA, Rogers PD. Mutations in TAC1B: a Novel Genetic Determinant of Clinical Fluconazole Resistance in Candida auris. mBio. 2020, 11 (3) e00365-20; DOI: 10.1128/mBio.00365-20.
Furukawa T, van Rhijn N, Fraczek M, Gsaller F, Davies E, Carr P, Gago S, Fortune-Grant R, Rahman S, Gilsenan JM, Houlder E, Kowalski CH, Raj S, Paul S, Cook P, Parker JE, Kelly SL, Cramer RA, Latgé J-P, Moye-Rowley S, Bignell E, Bowyer P, Bromley MJ. The negative cofactor 2 complex is a key regulator of drug resistance in Aspergillus fumigatus. Nature Communications. 2020, 427.
Morgan SR, Pilia N, Hewitt M, Moses RL, Moseley R, Lewis PN, Morrison PWJ, Kelly SL, Parker JE, Whitaker D, Quantock AJ, Heard CM. Controlled in vitro delivery of voriconazole and diclofenac to the cornea using contact lenses for the treatment of Acanthamoeba keratitis. International Journal of Pharmaceutics. 2020, https://doi.org/10.1016/j.ijpharm.2020.119102.
2019
Kannan A, Asner SA, Trachsel E, Kelly SL, Parker JE, Sanglard D. Comparative Genomics for the Elucidation of Multidrug Resistance in Candida lusitaniae. mBio. 2019, DOI: 10.1128/mBio.02512-19.
Warrilow AGS, Parker JE, Price CL, Rolley NJ, Nes WD, Kelly DE, Kelly SL. Isavuconazole and voriconazole inhibition of sterol 14α-demethylases (CYP51) from Aspergillus fumigatus and Homo sapiens. International Journal of Antimicrobial Agents. 2019, EPub before print.
Plácido J, Bustamante-López S, Meissner KE, Kelly DE, Kelly SL. NanoRefinery of carbonaceous nanomaterials: Complementing dairy manure gasification and their applications in cellular imaging and heavy metal sensing. Science of The Total Environment. 2019, 689, 10-20.
Plácido J, Bustamante-López S, Meissner KE, Kelly DE, Kelly SL. Multivariate analysis of biochar-derived carbonaceous nanomaterials for detection of heavy metal ions in aqueous systems. Science of The Total Environment. 2019, 688, 751-761.
Lamb DC, Follmer AH, Goldstone JV, Nelson DR, Warrilow AG, Price CL, True MY, Kelly SL, Poulos TL, Stegeman JJ. On the occurrence of cytochrome P450 in viruses. 2019. DOI: 10.1073/pnas.1901080116.
Rybak JM, Ge W, Wiederhold NP, Parker JE, Kelly SL, Rogers PD, Fortwendel JR. Mutations in hmg1, challenging the paradigm of clinical triazole resistance in Aspergillus fumigatus. mBio. 2019, DOI: 10.1128/mBio.00437-19.
Nishimoto AT, Wiederhold NP, Flowers SA, Zhang Q, Kelly SL, Morschhäuser J, Yates CM, Hoekstra WJ, Schotzinger RJ, Garvey EP, Rogers PD. In vitro activities of the novel investigational tetrazoles VT-1161 and VT-1598 compared to the triazole antifungals against azole-resistant strains and clinical isolates of Candida albicans. Antimicrobial Agents and Chemotherapy. 2019, DOI: 10.1128/AAC.00341-19.
Warrilow AG, Nishimoto AT, Parker JE, Price CL, Flowers SA, Kelly DE, Rogers PD, Kelly SL. The evolution of azole resistance in Candida albicans sterol 14α-demethylase (CYP51) through incremental amino acid substitutions. Antimicrobial Agents and Chemotherapy. 2019, EPub before print.
Plácido J, Bustamante-López S, Meissner KE, Kelly DE, Kelly SL. Microalgae biochar-derived carbon dots and their application in heavy metal sensing in aqueous systems. Science of the Total Environment. 2019, 656, 531-539.
Griffiths WJ, Crick PJ, Meljon A, Theofilopoulos S, Abdel-Khalik J, Yutuc E, Parker JE, Kelly DE, Kelly SL, Arenas E, Wang Y. Additional pathways of sterol metabolism: Evidence from analysis of Cyp27a1-/- mouse brain and plasma. Biochimica et biophysica acta. Molecular and Cell Biology of Lipids. 2019, DOI: 10.10.1016/j.bbalip.2018.11.006.
Ahmad S, Joseph L, Parker JE, Asadzadeh M, Kelly SL, Meis JF, Khan Z. ERG6 and ERG2 are major targets conferring reduced susceptibility to amphotericin B in clinical Candida glabrata isolates in Kuwait. Antimicrobial Agents and Chemotherapy. 2019, DOI: 10.1128/AAC.01900-18.
Cancer therapyDyson US Patent App. 15/774,569, 2019
Townsend, R., Van Keulen, G., Desbrow, C., & Godfrey, R. (2020). An investigation of the utility of QuEChERS for extracting acid, base, neutral and amphiphilic species from example environmental and clinical matrices. Analytical Science Advances 1(3):152-160 https://doi.org/10.1002/ansa.202000018 , SU Repository: https://cronfa.swan.ac.uk/Record/cronfa54329
2018
Mejia A, Luna D, Fernandez D, Barrios-Gonzalez J, Gutierrez LH, Reyes AG, Absalon AE, Kelly SL. Improving rifamycin production in Amycolatopsis mediterranei by expressing a Vitreoscilla hemoglobin (vhb) gene fused a cytochrome P450 monooxygenase domain. 3 Biotech. 2018. 8: 456.
Zhou W, Warrilow AGS, Thomas CD, Ramos E, Parker JE, Price CL, Vanderloop BH, Fisher PM, Loftis MD, Kelly DE, Kelly SL, Nes WD. Functional importance for developmental regulation of sterol biosynthesis in Acanthamoeba castellanii. Biochimica et Biophysica Acta (BBA) - Molecular and Cell Biology of Lipids. 2018. In Press.
Luna-Tapia A, Willems HM, Parker JE, Tournu H, Barker KS, Nishimoto AT, Rogers PD, Kelly SL, Peters BM, Palmer GE. Loss of Upc2p-inducible ERG3 transcription is sufficient to confer niche-specific azole resistance without compromising Candida albicans pathogenicity. mBio. 2018, 9:e00225-18.
Colley T, Sehra G, Chowdhary A, Alanio A, Kelly SL, Kizawa Y, Armstrong-James D, Fisher MC, Warrilow AGS, Parker JE, Kelly DE, Kimura G, Nishimoto Y, Sunose M, Onions S, Crepin D, Lagasse F, Crittall M, Shannon J, McConville M, King-Underwood J, Naylor A, Bretagne S, Murray J, Ito K, Strong P, Rapeport G. In vitro and in vivo efficacy of a novel and long acting fungicidal azole, PC1244, on Aspergillus fumigatus infection. Antimicrobial Agents and Chemotherapy. 2018, doi: 10.1128/AAC.01941-17
A novel alkaliphilic Streptomyces inhibits ESKAPE pathogens (2018) Luciana Terra, Paul J Dyson, Matthew D Hitchings, Liam Thomas, Alyaa Abdelhameed, Ibrahim M Banat, Salvatore A Gazze, Dušica Vujaklija, Paul D Facey, Lewis W Francis, Gerry A Quinn. Frontiers in Microbiology 9, 2458
Gazze, S., Hallin, I., Quinn, G., Dudley, E., Matthews, G., Rees, P., Van Keulen, G., Doerr, S., & Francis, L. (2018). Organic matter identifies the nano-mechanical properties of native soil aggregates. Nanoscale, 10(2), 520-525. https://doi.org/10.1039/C7NR07070E , SU Repository: https://cronfa.swan.ac.uk/Record/cronfa37598
2017
Sewell TR, Hawkins NJ, Stotz HU, Huang YJ, Kelly SL, Kelly DE, Fraaije B, Fitt BDL. Azole sensitivity in Leptosphaeria pathogens of oilseed rape: the role of lanosterol 14alpha-demethylase. Scientific Reports. 2017, 7:15849.
Butts A, DeJarnette C, Peters TL, Parker JE, Kerns ME, Eberle KE, Kelly SL, Palmer GE. Target abundance-based fitness screening (TAFiS) facilitates rapid identification of target-specific and physiologically active chemical probes. mSphere. 2017, DOI: 10.1128/mSphere.00379-17.
Hull CM, Warrilow AGS, Rolley NJ, Price CL, Donnison IS, Kelly DE, Kelly SL. Co-production of 11alpha-hydroxyprogesterone and ethanol using recombinant yeast expressing fungal steroid hydroxylases. Biotechnol Biofuels. 2017, 10:226.
Lemaire B, Karchner SI, Goldstone JV, Lamb DC, Drazen JC, Rees JF, Hahn ME, Stegeman JJ. Molecular adaptation to high pressure in cytochrome P450 1A and aryl hydrocarbon receptor systems of the deep-sea fish Coryphaenoides armatus. Biochimica et Biophysica Acta (BBA) - Proteins and Proteomics. 2017, EPub ahead of print.
Rybak JM, Dicken CM, Parker JE, Caudle K, Manigaba K, Whaley SG, Nishimoto A, Luna-Tapia A, Roy S, Zhang Q, Barker KS, Palmer GE, Sutter TR, Homayouni R, Wiederhold NP, Kelly SL, Rogers PD. Loss of C-5 sterol desaturase activity results in increased resistance to azole and echinocandin antifungals in a clinical isolate of Candida parapsilosis. Antimicrobial Agents and Chemotherapy. 2017, doi: 10.1128/AAC.00651-17.
Warrilow AGS, Parker JE, Price CL, Garvey EP, Hoekstra WJ, Schotzinger RJ, Wiederhold NP, Nes WD, Kelly DE, Kelly SL. The tetrazole VT-1161 is a potent inhibitor of Trichophyton rubrum through its inhibition of T. rubrum CYP51. Antimicrobial Agents and Chemotherapy. 2017, doi: 10.1128/AAC.00333-17.
Colley T, Alanio A, Kelly SL, Sehra G, Kizawa Y, Warrilow AGS, Parker JE, Kelly DE, Kimura G, Anderson-Dring L, Nakaoki T, Sunose M, Onions S, Crepin D, Lagasse F, Crittall M, Shannon J, Cooke M, Bretagne S, King-Underwood J, Murray J, Ito K, Strong P, Rapeport G. In vitro and in vivo antifungal profile of a novel and long acting inhaled azole, PC945, on Aspergillus fumigatus infection. Antimicrobial Agents and Chemotherapy. 2017, doi:10.1128/AAC.02280-16.
Gene silencing in non‐model insects: Overcoming hurdles using symbiotic bacteria for trauma‐free sustainable delivery of RNA interference: Sustained RNA interference in insects mediated by symbiotic bacteria: Applications as a genetic tool and as a biocide (2017) Miranda Whitten, Paul Dyson. Bioessays 39 (3), 1600247
2016
McCourt P, Liu H-Y, Parker JE, Gallo-Ebert C, Donigan M, Bata A, Giordano C, Kelly SL, Nickels Jr JT. Proper sterol distribution is required for Candida albicans hyphal formation and virulence. G3: Genes, Genomes, Genetics. 2016, doi: 10.1534/g3.116.033969.
Warrilow AG, Price CL, Parker JE, Rolley NJ, Smyrniotis CJ, Hughes DD, Thoss V, Nes WD, Kelly DE, Holman TR, Kelly SL. Azole antifungal sensitivity of sterol 14α-demethylase (CYP51) and CYP5218 from Malassezia globosa. Scientific Reports. 2016, 6, 27690.
Warrilow AG, Parker JE, Price CL, Nes WD, Garvey EP, Hoekstra WJ, Schotzinger RJ, Kelly DE, Kelly SL. The investigational drug VT-1129 is a highly potent inhibitor of Cryptococcus species CYP51 but only weakly inhibits the human enzyme. Antimicrobial Agents and Chemotherapy. 2016. 60(8), 4530-4538.
Lemaire B, Kubota A, O'Meara CM, Lamb DC, Tanguay RL, Goldstone JV, Stegeman JJ. Cytochrome P450 20A1 in zebrafish: cloning, regulation and potential involvement in hyperactivity disorders. Toxicology and Applied Pharmacology. 2016, EPub ahead of print.
Goldstone JV, Sundaramoorthy M, Zhao B, Waterman MR, Stegeman JJ, Lamb DC. Genetic and structural analyses of cytochrome P450 hydroxylases in sex hormone biosynthesis: sequential origin and subsequent coevolution. Molecular Phylogenetics and Evolution. 2016, 94 Part B, 676-687.
Symbiont-mediated RNA interference in insects (2016) Miranda MA Whitten, Paul D Facey, Ricardo Del Sol, Lorena T Fernández-Martínez, Meirwyn C Evans, Jacob J Mitchell, Owen G Bodger, Paul J Dyson. Proceedings of the Royal Society B: Biological Sciences 283 (1825), 20160042
2015
Warrilow AGS, Parker JE, Price CL, Nes WD, Kelly SL, Kelly DE. CYP51-mediated azole resistance in Aspergillus fumigatus: an in vitro biochemical study. Antimicrobial Agents and Chemotherapy. 2015, 59(12), 7771-7778.
Hargrove TY, Wawrzak Z, Lamb DC, Guengerich FP, Lepesheva GI. Structure-functional characterization of cytochrome P450 sterol 14alpha-demethylase (CYP51B) from Aspergillus fumigatus and molecular basis for the development of antifungal drugs. The Journal of Biological Chemistry. 2015, 290(39), 23916-23934.
Berkow El, Manigaba K, Parker JE, Barker KS, Kelly SL, Rogers PD. Multidrug transporters and alterations in sterol biosynthesis contribute to azole antifungal resistance in Candida parapsilosis. Antimicrobial Agents and Chemotherapy. 2015, 59(10), 5942-5950.
Derbyshire MC, Michaelson L, Parker J, Kelly S, Thacker U, Powers SJ, Bailey A, Hammond-Kosack K, Courbot M, Rudd J. Analysis of cytochrome b5 reductase-mediated metabolism in the phytopathogenic fungus Zymoseptoria tritici reveals novel functionalities implicated in virulence. Fungal Genetics and Biology. 2015, 82, 69-84.
Lamb DC, Warrilow AG, Rolley NJ, Parker JE, Nes WD, Smith SN, Kelly DE, Kelly SL. Azole antifungal agents to treat the human pathogens Acanthamoeba castellanii and Acanthamoeba polyphaga through inhibition of sterol 14alpha-demethylase (CYP51). Antimicrobial Agents and Chemotherapy. 2015, 59(8), 4707-4713.
Price CL, Parker JE, Warrilow AGS, Kelly DE, Kelly SL. Azole fungicides - understanding resistance mechanisms in agricultural fungal pathogens. Pest Management Science. 2015, 71(8), 1054-1058.
Price CL, Warrilow AGS, Parker JE, Mullins JGL, Nes WD, Kelly DE, Kelly SL. Novel substrate specificity and temperature sensitive activity of Mycosphaerella graminicola CYP51 (MgCYP51) supported by the native NADPH cytochrome P450 reductase (CPR). Applied and Environmental Microbiology. 2015, 81(10), 3379-3386.
2014
Morrison AM, Goldstone JV, Lamb DC, Kubota A, Lemaire B, Stegeman JJ. Identification, modeling and ligand affinity of early deuterostome CYP51s, and functional characterization of recombinant zebrafish sterol 14alpha-demethylase. Biochimia et biophysica acta. 2014, 1840(6), 1825-1836.
Salvage R, Hull CM, Kelly DE, Kelly SL. Use of 70% alcohol for the routine removal of microbial hard surface bioburden in life science cleanrooms. Future Microbiology. 2014, 9(10), 1123-1130.
Hull CM, Loveridge EJ, Donnison IS, Kelly DE, Kelly SL. Co-production of bioethanol and probiotic yeast biomass from agricultural feedstock: application of the rural biorefinery concept. AMB Express. 2014, 4, Epub.
Hull CM, Loveridge EJ, Rolley NJ, Donnison IS, Kelly SL, Kelly DE. Co-production of ethanol and squalene using a Saccharomyces cerevisiae ERG1 (squalene epoxidase) mutant and agro-industrial feedstock. Biotechnology for Biofuels. 2014, 7, Epub.
Warrilow AGS, Hull CM, Parker JE, Garvey EP, Hoekstra WJ, Moore WR, Schotzinger RJ, Kelly DE, Kelly SL. The clinical candidate VT-1161 is a highly potent inhibitor of Candida albicans CYP51 but fails to bind the human enzyme. Antimicrobial Agents and Chemotherapy. 2014, Epub.
Parker JE, Warrilow AGS, Price CL, Mullins JGL, Kelly DE, Kelly SL. Resistance to antifungals that target CYP51. Journal of Chemical Biology. 2014, 7(4), 143-161.
Warrilow AGS, Hull CM, Rolley NJ, Parker JE, Nes WD, Smith SN, Kelly DE, Kelly SL. Clotrimazole as a potent agent for treating the oomycete fish pathogen Saprolegnia parasitica through inhibition of sterol 14alpha-demethylase (CYP51). Applied and Environmental Microbiology. 2014. 80(19), 6154-6166.
Hawkins NJ, Cools HJ, Sierotzki H, Shaw MW, Knogge W, Kelly SL, Kelly DE, Fraaije BA. Paralog re-emergence: a novel, historically contingent mechanism in the evolution of antimicrobial resistance. Molecular Biology and Evolution. 2014, 31(7), 1793-1802.
Carter HE, Fraaije BA, West JS, Kelly SL, Mehl A, Shaw MW, Cools HJ. Alterations in the predicted regulatory and coding regions of the sterol 14alpha-demethylase gene (CYP51) confer decreased azole sensitivity in the oilseed rape pathogen Pyrenopeziza brassicae. Molecular Plant Pathology 2014, 15(5), 513-522.